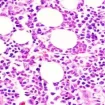

To determine the number of researchers required for a region to be a leader in a field, experts at the
A review directed by scientists from the Gallery for Naturkunde in Berlin uncovered the development of solidification designs in the spines of four-legged vertebrates. Antoine Verrière and his partners had